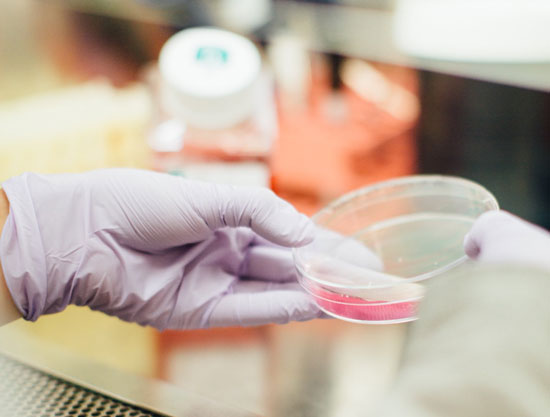

Respaldo y asesoría médica
The Blissful MD es una empresa formada por científicos mexicanos, especialistas en salud mental y en el sistema endocannabinoide.
The Blissful MD cuenta con 4 formulaciones dirigidas a receptores del sistema endocannabinoide buscando mejorar la calidad de vida de quien lo consume.

FILOSOFÍA
The Blissful MD ofrece una solución natural y equilibrada para mejorar el bienestar físico y mental a través de suplementos alimenticios a base de CBD.
MISIÓN
Introducir de manera transparente el CBD como suplemento alimenticio en una industria de rápido crecimiento proporcionando productos de alta calidad para mejorar el bienestar y la calidad de vida del usuario.
VISIÓN
Ser la mejor compañía de soluciones con CBD para mejorar el bienestar y calidad de vida del usuario.
VALORES
Responsabilidad, pasión, calidad, integridad, colaboración, innovación, trabajo en equipo e impacto social.

Te podemos ayudar
El Sistema Endocannabinoide es un sistema de neurotransmisión que existe en el cerebro y varios tejidos corporales encargado de procesos fisiológicos como la liberación de otros neurotransmisores, la regulación y percepción del dolor, la relajación, el sueño y la consolidación de la memoria.
The Blissful MD presenta 4 formulaciones a base de aceite de triglicéridos de cadena media que favorecen la solubilidad, biodisponibilidad y absorción de los fitocannabinoides y terpenos de la más alta calidad para aprovechar los efectos fisiológicos del CBD como antiinflamatorio, neuroprotector y ansiolítico.
El aceite de CBD de Blissful MD ayuda a mejorar la comunicación sináptica entre neuronas y a regular procesos fisiológicos alterados por enfermedades presentes, pasadas, por estrés o por otras situaciones ambientales.

Nuestros productos y socios se enfocan en el equilibrio natural del tratamiento integral,
marca con el respaldo de médicos especialistas con la única finalidad de mejorar
el bienestar y la calidad de vida del usuario.
